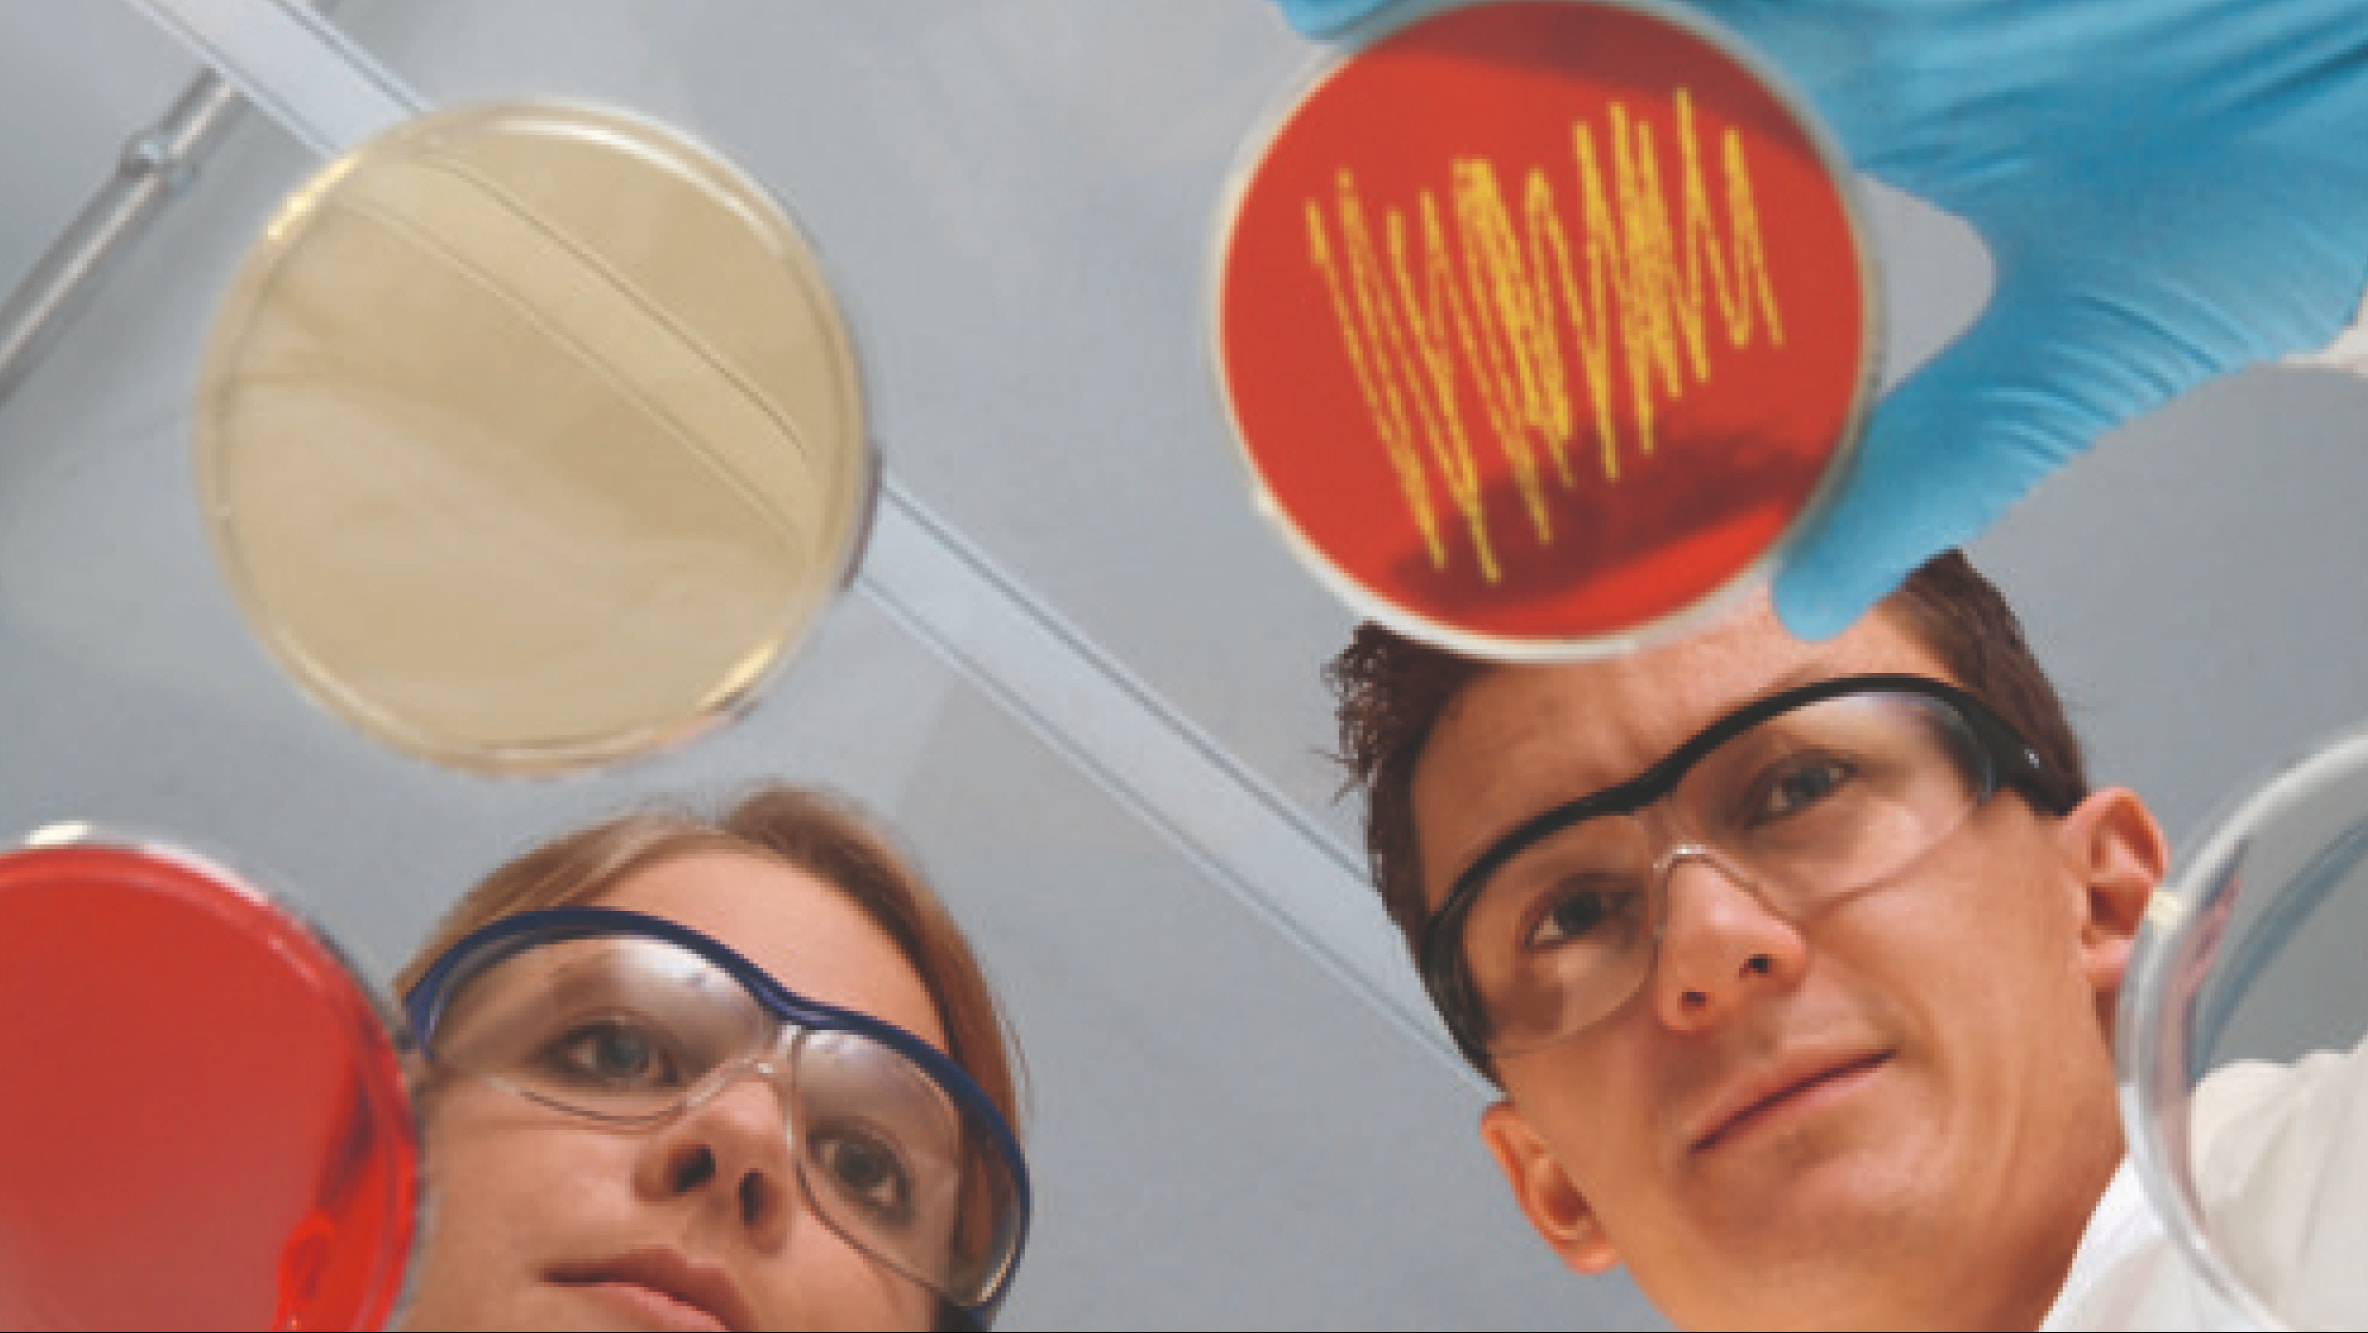
Un homme et une femme, avec des lunettes de protection de laboratoire, manipulent plusieurs boîtes de Pétri avec des échantillons

Pour une meilleure santé des poumons – tout au long de l’année
Le changement de saison signifie pour la plupart un nouveau départ. Un renouveau. Une occasion de regarder vers l’avenir et de passer du temps avec ses proches.

Mais pour les personnes atteintes d’affections pulmonaires, une nouvelle saison ne signifie pas pour autant aller mieux. En effet, les personnes vivant avec une fibrose pulmonaire (FP) présentent chaque jour des symptômes qui, au fil du temps, s’aggravent progressivement, rendant la respiration encore plus difficile même au repos.
Boehringer Ingelheim aborde cette maladie dans le cadre du Mois de Sensibilisation à la Fibrose Pulmonaire (MSFP) en septembre et met l’accent sur quatre maladies associées à la FP.
Nous mettons l'accent sur la pneumopathie interstitielle associée

à une sclérose systémique (PPI-ScS), une maladie qui provoque la formation de tissus cicatriciels dans les poumons. Si vous présentez des symptômes de PPI-ScS, une toux persistante et un essoufflement notamment, n'attendez pas. Parlez-en à votre médecin. Un diagnostic précoce contribue largement à la santé et la qualité de vie à long terme. La promesse de vivre encore plus de moments précieux avec vos proches.
Fibrose pulmonaire idiopathique (FPI)
La FPI est une maladie pulmonaire chronique et invalidante qui entraîne au fil du temps une cicatrisation permanente des poumons, se traduisant par un essoufflement et une toux. Elle est qualifiée d’ »idiopathique » car la cause de la maladie est inconnue. Bien que le déclin de la fonction pulmonaire soit irréversible, un diagnostic précoce et précis ainsi qu’un traitement rapide peut toutefois ralentir la progression de la maladie. La FPI affecte principalement les patients de plus de 50 ans et touche davantage les hommes que les femmes.

Pneumopathie interstitielle associée à une sclérose systémique (PPI-ScS)
La sclérodermie est une maladie auto-immune, rhumatismale et chronique qui provoque le durcissement du tissu conjonctif affectant la peau sur l’ensemble du corps.
Lorsque la maladie affecte les organes du corps, on parle alors de sclérose systémique. La cicatrisation (durcissement) de la peau et des poumons peut être invalidante et menacer le pronostic vital.
Les patients atteints de PPI-ScS ont un risque élevé de développer une FP. Elle peut entraîner un déclin fonctionnel et entraver la respiration, elle constitue également la principale cause de décès en lien avec la maladie. La maladie touche les personnes âgées de 25 à 55 ans, les femmes étant quatre fois plus exposées que les hommes.

Pneumopathie interstitielle associée à une polyarthrite rhumatoïde (PPI-PR)
La polyarthrite rhumatoïde (PR) est une affection qui touche près de 1% de la population mondiale. La polyarthrite rhumatoïde (PR) est une maladie auto-immune chronique et systémique qui touche principalement les articulations. Les réactions inflammatoires chroniques ne se limitent pas aux articulations de l'appareil locomoteur, mais peuvent également toucher d'autres organes comme les poumons.
La formation d’une inflammation ou d’une cicatrisation dans les structures de soutien des poumons appelées interstitium serait une des voies qui pourraient affecter les poumons et causer une PPI-PR. Cela signifie que la cicatrisation rend l'échange d'oxygène entre les alvéoles pulmonaires et les vaisseaux sanguins plus difficile et, dans le pire des cas, impossible. La formation de tissus cicatriciels induit alors une traction sur les voies respiratoires des poumons entraînant ainsi une toux, souvent le premier symptôme, qui empêche l’oxygène de pénétrer dans l’organisme et provoque une dyspnée.
Au cours de son évolution, la maladie se traduit manifestement par un essoufflement lors des exercices physiques et des activités au quotidien.
Les principaux facteurs de risque sont le tabagisme, un âge avancé, le sexe masculin et la gravité de la PR.
Pneumopathie d’hypersensibilité (PHS)
La PHS est une pneumopathie interstitielle (PPI) rare qui n’affecte chaque année que 2 à 3 personnes sur 100'000.
Elle survient lorsque les poumons développent une réponse immunitaire (hypersensibilité) à une substance inhalée, ce qui entraîne une inflammation du tissu pulmonaire appelée pneumopathie. Certaines personnes développent également une fibrose pulmonaire – une inflammation rendant difficile la respiration et pouvant entraîner, au fil du temps, la formation irréversible de tissus cicatriciels dans les poumons et empêcher ainsi une alimentation suffisante en oxygène des tissus de l’organisme. Les symptômes comprennent un essoufflement, une respiration rapide et superficielle, une toux sèche, une fatigue ainsi qu’un hippocratisme des doigts et des orteils. Les personnes exerçant certaines professions sont plus sujettes à développer une PHS comme par exemple certains fermiers et éleveurs d’oiseaux.

Comment soutenir les personnes atteintes de fibrose pulmonaire (FP) ?
Boehringer Ingelheim est actif dans le domaine des affections respiratoires depuis plus de 100 ans. Grâce à l’engagement de la société de la fibrose pulmonaire et de Boehringer Ingelheim, des progrès significatifs furent réalisés pour ces maladies rares au cours de la dernière décennie. En renforçant la sensibilisation à cette maladie, nous espérons contribuer à améliorer le diagnostic, les soins et les résultats pour les personnes vivant avec la FP. Par nos travaux et nos efforts, nous visons à transformer la vie de nos patients – chaque jour.

Liens utiles
En renforçant la sensibilisation à cette maladie, nous espérons contribuer à améliorer le diagnostic, les soins et les résultats pour les personnes vivant avec la FP. Par nos travaux et nos efforts, nous visons à transformer la vie de nos patients – chaque jour.

